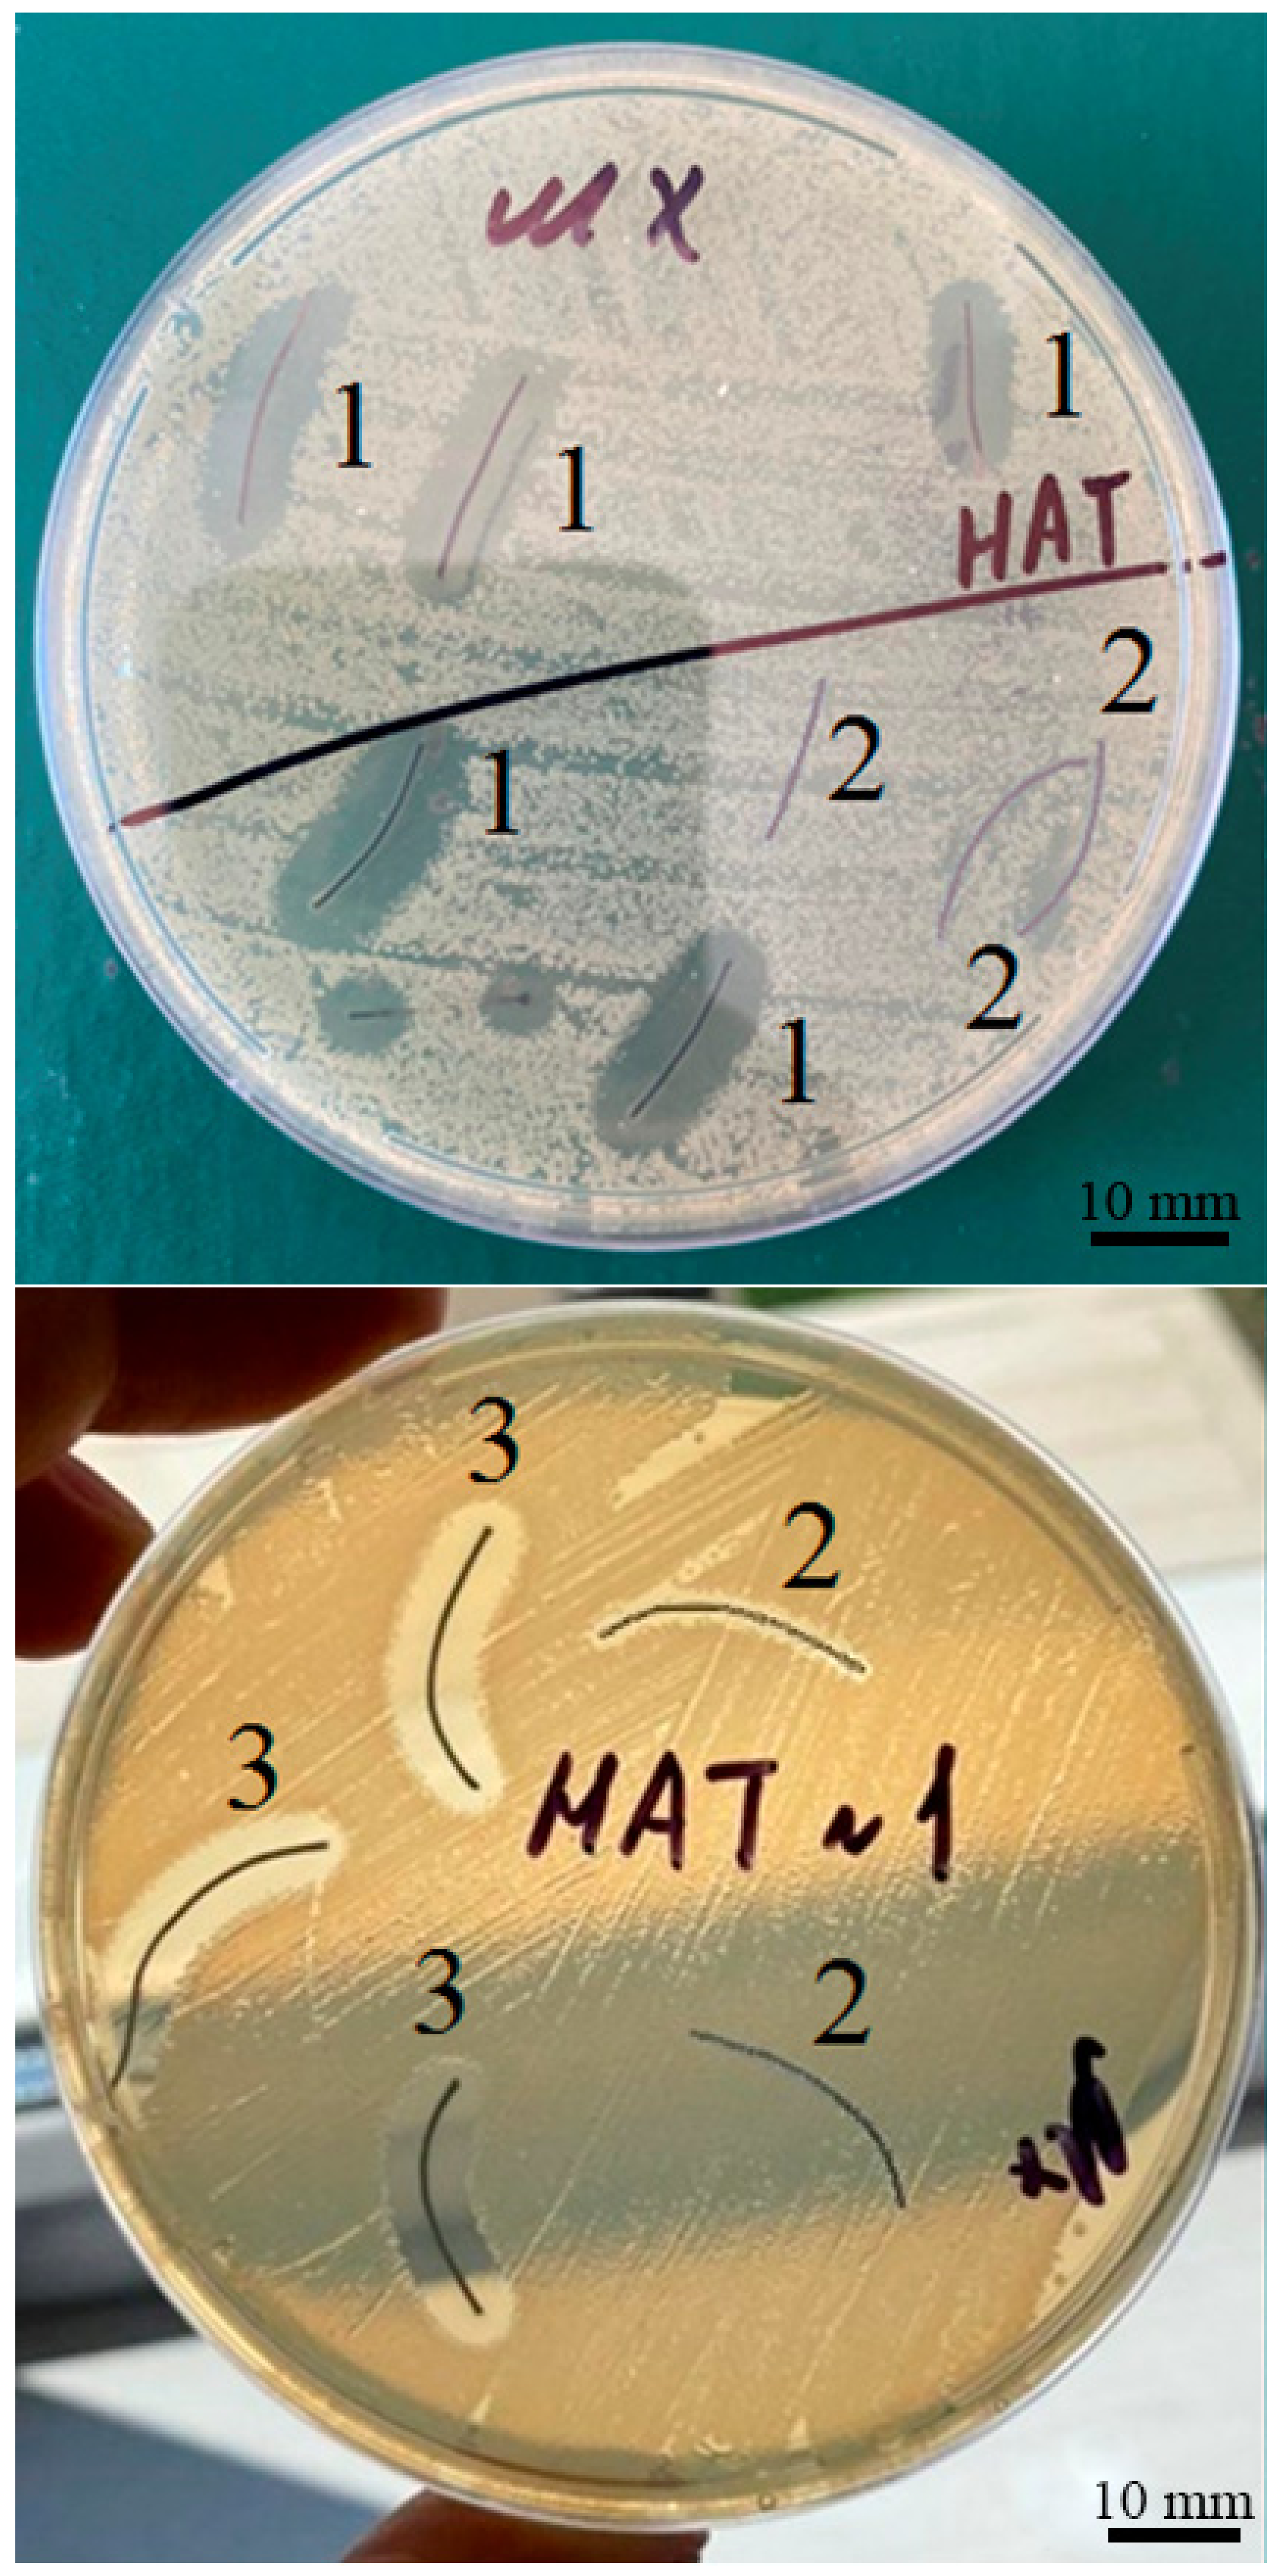
Nanomaterials 12 01164 g009

Changes in Number and Antibacterial Activity of Silver Nanoparticles on the Surface of Suture Materials during Cyclic Freezing
Abstract
:1. Introduction
2. Materials and Methods
2.1. Materials
2.2. Characterization Methods
2.3. Statistics
3. Results
4. Discussion
- -
- The increase in the number of nanoparticles on all suture materials investigated (silk, catgut, perlon) was observed when using cyclic freezing/thawing;
- -
- After cyclic freezing/thawing, AgNPs are distributed more homogeneously in size, while their number significantly predominates in the diameter range less than 16 nm: silk (99.5%) > perlon (92.7%) > catgut (82.9%);
- -
- The largest number of AgNPs with a diameter less than 6 nm after cyclic freezing/thawing was observed on silk fibers (96.7% of the total number of nanoparticles) and significantly prevailed over the same indicator on catgut and perlon;
- -
- The highest absolute and relative number of AgNPs with a diameter of more than 15 nm after cyclic freezing/thawing was observed on catgut;
- -
- The antibacterial activity of the silk fibers with AgNPs before and after cyclic freezing was higher than the perlon and catgut threads with nanoparticles (the zone of the bacterial growth inhibition before cyclic freezing was: silk > perlon > catgut as 100% > 50% > 32%, and after cyclic freezing it was: silk > perlon ≈ catgut as 100% > 40% ≈ 36%);
- -
- Differently from perlon threads with AgNPs, the antibacterial activities of the silk and catgut SMs with nanoparticles were significantly higher (1.5 and 1.7 times, respectively), after cyclic freezing.
5. Conclusions
Supplementary Materials
Author Contributions
Funding
Institutional Review Board Statement
Informed Consent Statement
Data Availability Statement
Acknowledgments
Conflicts of Interest
References
- Tubre, D.J.; Schroeder, A.D.; Estes, J.; Eisenga, J.; Fitzgibbons, R.J., Jr. Surgical site infection: The “Achilles Heel” of all types of abdominal wall hernia reconstruction. Hernia 2018, 22, 1003–1013. [Google Scholar] [CrossRef] [PubMed]
- Meyer, J.; Roos, E.; Abbassi, Z.; Buchs, N.C.; Ris, F.; Toso, C. Prophylactic negative-pressure wound therapy prevents surgical site infection in abdominal surgery: An updated systematic review and meta-analysis of randomized controlled trials and observational studies. Clin. Infect. Dis. 2020, 73, e3804–e3813. [Google Scholar] [CrossRef] [PubMed]
- Ruffolo, A.M.; Sampath, A.J.; Colbert, S.; Golda, N. Preoperative Considerations for the Prevention of Surgical Site Infection in Superficial Cutaneous Surgeries: A Systematic Review. Facial. Plast. Surg. Aesthet. Med. 2021, 23, 205–223. [Google Scholar] [CrossRef] [PubMed]
- Basov, A.A.; Fedosov, S.R.; Malyshko, V.V.; Elkina, A.A.; Lyasota, O.M.; Dzhimak, S.S. Evaluation of effectiveness of a new treatment method for healing infected wounds: An animal model. J. Wound Care 2021, 30, 312–322. [Google Scholar] [CrossRef]
- Nherera, L.M.; Trueman, P.; Roberts, C.D.; Berg, L. A systematic review and meta-analysis of clinical outcomes associated with nanocrystalline silver use compared to alternative silver delivery systems in the management of superficial and deep partial thickness burns. Burns 2017, 43, 939–948. [Google Scholar] [CrossRef]
- Tang, Q.; Chen, C.; Jiang, Y.; Huang, J.; Liu, Y.; Nthumba, P.M.; Gu, G.; Wu, X.; Zhao, Y.; Ren, J. Engineering an adhesive based on photosensitive polymer hydrogels and silver nanoparticles for wound healing. J. Mater. Chem. B 2020, 8, 5756–5764. [Google Scholar] [CrossRef]
- Chen, J.; Qiu, L.; Li, Q.; Ai, J.; Liu, H.; Chen, Q. Rapid hemostasis accompanied by antibacterial action of calcium crosslinking tannic acid-coated mesoporous silica/silver Janus nanoparticles. Mater. Sci. Eng. C Mater. Biol. Appl. 2021, 123, 111958. [Google Scholar] [CrossRef]
- Edis, Z.; Haj Bloukh, S.; Ibrahim, M.R.; Abu Sara, H. “Smart” Antimicrobial Nanocomplexes with Potential to Decrease Surgical Site Infections (SSI). Pharmaceutics 2020, 12, 361. [Google Scholar] [CrossRef] [Green Version]
- Petriev, I.S.; Bolotin, S.N.; Frolov, V.Y.; Baryshev, M.G.; Isaev, V.A.; Kopytov, G.F. Modifying the surface of a hydrogen permselective palladium–silver membrane. Bull. Rus. Acad. Sci. Phys. 2016, 80, 624–626. [Google Scholar] [CrossRef]
- Petriev, I.S.; Frolov, V.Y.; Bolotin, S.N.; Baryshev, M.G.; Kopytov, G.F. A Surface-Modified Hydrogen-Permeable Palladium-Silver Plate. Rus. Phys. J. 2015, 58, 1044–1048. [Google Scholar] [CrossRef]
- Pandey, P.C.; Mitra, M.D.; Shukla, S.; Narayan, R.J. Organotrialkoxysilane-Functionalized Noble Metal Monometallic, Bimetallic, and Trimetallic Nanoparticle Mediated Non-Enzymatic Sensing of Glucose by Resonance Rayleigh Scattering. Biosensors 2021, 11, 122. [Google Scholar] [CrossRef] [PubMed]
- Akter, S.; Huq, M.A. Biologically rapid synthesis of silver nanoparticles by Sphingobium sp. MAH-11(T) and their antibacterial activity and mechanisms investigation against drug-resistant pathogenic microbes. Artif. Cells Nanomed. Biotechnol. 2020, 48, 672–682. [Google Scholar] [CrossRef] [PubMed] [Green Version]
- Zhao, D.H.; Yang, J.; Yao, M.H.; Li, C.Q.; Zhang, B.; Zhu, D.; Zhao, Y.D.; Liu, B. An in situ synthesis of silver nanoparticle-loaded genetically engineered polypeptide nanogels for antibacterial and wound healing applications. Dalton Trans. 2020, 49, 12049–12055. [Google Scholar] [CrossRef] [PubMed]
- Zapor, L. Effects of silver nanoparticles of different sizes on cytotoxicity and oxygen metabolism disorders in both reproductive and respiratory system cells. Arch. Environ. Prot. 2016, 42, 32–47. [Google Scholar] [CrossRef] [Green Version]
- Bélteky, P.; Rónavári, A.; Zakupszky, D.; Boka, E.; Igaz, N.; Szerencsés, B.; Pfeiffer, I.; Vágvölgyi, C.; Kiricsi, M.; Kónya, Z. Are Smaller Nanoparticles Always Better? Understanding the Biological Effect of Size-Dependent Silver Nanoparticle Aggregation Under Biorelevant Conditions. Int. J. Nanomed. 2021, 16, 3021–3040. [Google Scholar] [CrossRef]
- Ganash, E.A.; Altuwirqi, R.M. Size Control of Synthesized Silver Nanoparticles by Simultaneous Chemical Reduction and Laser Fragmentation in Origanum majorana Extract: Antibacterial Application. Materials 2021, 14, 2326. [Google Scholar] [CrossRef]
- Baygar, T. Characterization of silk sutures coated with propolis and biogenic silver nanoparticles (AgNPs); an eco-friendly solution with wound healing potential against surgical site infections (SSIs). Med. Sci. 2020, 50, 258–266. [Google Scholar] [CrossRef]
- Thapa, R.; Bhagat, C.; Shrestha, P.; Awal, S.; Dudhagara, P. Enzyme-mediated formulation of stable elliptical silver nanoparticles tested against clinical pathogens and MDR bacteria and development of antimicrobial surgical thread. Ann. Clin. Microbiol. Antimicrob. 2017, 16, 39. [Google Scholar] [CrossRef] [Green Version]
- Gouyau, J.; Duval, R.E.; Boudier, A.; Lamouroux, E. Investigation of Nanoparticle Metallic Core Antibacterial Activity: Gold and Silver Nanoparticles against Escherichia coli and Staphylococcus aureus. Int. J. Mol. Sci. 2021, 22, 1905. [Google Scholar] [CrossRef]
- Hamida, R.S.; Ali, M.A.; Goda, D.A.; Al-Zaban, M.I. Lethal Mechanisms of Nostoc-Synthesized Silver Nanoparticles Against Different Pathogenic Bacteria. Int. J. Nanomed. 2020, 15, 10499–10517. [Google Scholar] [CrossRef]
- Dzhimak, S.S.; Malyshko, V.V.; Goryachko, A.I.; Sokolov, M.E.; Basov, A.A.; Moiseev, A.V.; Shashkov, D.I.; Kopytov, G.F.; Baryshev, M.G.; Isaev, V.A. Sorption activity of silver nanoparticles. Rus. Phys. J. 2019, 62, 314–322. [Google Scholar] [CrossRef]
- Dzhimak, S.S.; Malyshko, V.V.; Goryachko, A.I.; Sokolov, M.E.; Moiseev, A.V.; Basov, A.A. Adsorption of Silver Nanoparticles on Mono- and Polyfilament Fibers. Nanotechol. Rus. 2019, 14, 48–54. [Google Scholar] [CrossRef]
- Jeong, Y.; Lim, D.W.; Choi, J. Assessment of Size-Dependent Antimicrobial and Cytotoxic Properties of Silver Nanoparticles. Adv. Mater. Sci. Eng. 2014, 2014, 763807. [Google Scholar] [CrossRef] [Green Version]
- Sotiriou, G.A.; Pratsinis, S.E. Antibacterial activity of nanosilver ions and particles. Environ. Sci. Technol. 2010, 44, 5649–5654. [Google Scholar] [CrossRef]
- Hussain, S.M.; Hess, K.L.; Gearhart, J.M.; Geiss, K.T.; Schlager, J.J. In vitro toxicity of nanoparticles in BRL 3A rat liver cells. Toxic. Vit. 2005, 19, 975–983. [Google Scholar] [CrossRef] [PubMed]
- Roe, D.; Karandikar, B.; Bonn-Savage, N.; Gibbins, B.; Roullet, J.-B. Antimicrobial surface functionalization of plastic catheters by silver nanoparticles. J. Antimicrob. Chemother. 2008, 61, 869–876. [Google Scholar] [CrossRef]
- Raza, M.A.; Kanwal, Z.; Rauf, A.; Sabri, A.N.; Riaz, S.; Naseem, S. Size- and Shape-Dependent Antibacterial Studies of Silver Nanoparticles Synthesized by Wet Chemical Routes. Nanomaterials 2016, 6, 74. [Google Scholar] [CrossRef] [Green Version]
- Pal, S.; Tak, Y.K.; Song, J.M. Does the Antibacterial Activity of Silver Nanoparticles Depend on the Shape of the Nanoparticle? A Study of the Gram-Negative Bacterium Escherichia coli. Appl. Environ. Microbiol. 2007, 73, 1712–1720. [Google Scholar] [CrossRef] [Green Version]
- Dong, P.V.; Ha, C.H.; Binh, L.T.; Kasbohm, J. Chemical synthesis and antibacterial activity of novel-shaped silver nanoparticles. Int. Nano Lett. 2012, 2, 9. [Google Scholar] [CrossRef] [Green Version]
- Morones, J.R.; Elechiguerra, J.L.; Camacho, A.; Holt, K.; Kouri, J.B.; Ramirez, J.T.; Yacaman, M.J. The bactericidal effect of silver nanoparticles. Nanotechnology 2005, 16, 2346–2353. [Google Scholar] [CrossRef] [Green Version]
- Ho, C.H.; Odermatt, E.K.; Berndt, I.; Tiller, J.C. Long-term active antimicrobial coatings for surgical sutures based on silver nanoparticles and hyperbranched polylysine. J. Biomater. Sci. Polym. Ed. 2013, 24, 1589–5600. [Google Scholar] [CrossRef] [PubMed]
- Tarusha, L.; Paoletti, S.; Travan, A.; Marsich, E. Alginate membranes loaded with hyaluronic acid and silver nanoparticles to foster tissue healing and to control bacterial contamination of non-healing wounds. J. Mater. Sci. Mater. Med. 2018, 29, 22. [Google Scholar] [CrossRef] [PubMed] [Green Version]
- Guo, X.; Yin, Y.; Tan, Z.; Liu, J. Environmentally Relevant Freeze-Thaw Cycles Enhance the Redox-Mediated Morphological Changes of Silver Nanoparticles. Environ. Sci. Technol. 2018, 52, 6928–6935. [Google Scholar] [CrossRef]
- Tan, Z.; Guo, X.; Yin, Y.; Wang, B.; Bai, Q.; Li, X.; Liu, J.; Jiang, G. Freezing Facilitates Formation of Silver Nanoparticles under Natural and Simulated Sunlight Conditions. Environ. Sci. Technol. 2019, 53, 13802–13811. [Google Scholar] [CrossRef] [PubMed]
- Tang, S.; Zheng, J. Antibacterial activity of silver nanoparticles: Structural effects. Adv. Healthc. Mater. 2018, 7, e1701503. [Google Scholar] [CrossRef] [PubMed]
- Das, A.C.G.; Kumar, V.G.; Dhas, T.S.; Karthick, V.; Govindaraju, K.; Joselin, J.M.; Baalamurugan, J. Antibacterial activity of silver nanoparticles (biosynthesis): A short review on recent advances. Biocatal. Agric. Biotechnol. 2020, 27, 101593. [Google Scholar] [CrossRef]
- Basov, A.A.; Malyshko, V.V.; Fedosov, S.R.; Savchenko, Y.P.; Vlasov, R.V.; Chernobay, K.N. Device for producing silver nanoparticles. Patent RU150504U1, 20 February 2015. [Google Scholar]
- Dzhimak, S.S.; Sokolov, M.E.; Basov, A.A.; Fedosov, S.R.; Malyshko, V.V.; Vlasov, R.V.; Lyasota, O.M.; Baryshev, M.G. Optimization of physicochemical conditions to produce silver nanoparticles and estimation of the biological effects of colloids synthesized. Nanotechnol. Rus. 2016, 11, 835–841. [Google Scholar] [CrossRef]
- Bungthong, C.; Siriamornpun, S. Changes in Amino Acid Profiles and Bioactive Compounds of Thai Silk Cocoons as Affected by Water Extraction. Molecules 2021, 26, 2033. [Google Scholar] [CrossRef]
- Görög, P.; Kakkar, V.V. Transient effect of aspirin on collagen-induced platelet accumulation. Am. J. Clin. Pathol. 1986, 86, 311–316. [Google Scholar] [CrossRef] [Green Version]
- Bhattacharjee, J.; Harinath, A.; Sarkar, A.; Panda, T.K. Polymerization of ε-Caprolactam to Nylon-6 Catalyzed by Barium σBorane Complex under Mild Condition. Chem. Cat. Chem. 2019, 11, 3366–3370. [Google Scholar] [CrossRef]
- ISO 13322-1; Particle Size Analysis—Image Analysis Methods—Part 1: Static Image Analysis Methods. ISO: Geneva, Switzerland, 2004; p. 39. Available online: https://www.iso.org/obp/ui/#iso:std:iso:13322:-1:ed-1:v1:en (accessed on 21 December 2021).
- Wei, Y.; Huang, Y.H.; Cheng, K.C.; Song, Y.L. Investigations of the influences of processing conditions on the properties of spray dried chitosan-tripolyphosphate particles loaded with theophylline. Sci. Rep. 2020, 10, 1155. [Google Scholar] [CrossRef] [PubMed]
- Souza, D.O.C.; Menegalli, F.C. Image analysis: Statistical study of particle size distribution and shape characterization. Pow. Tech. 2011, 214, 57–63. [Google Scholar] [CrossRef]
- Fan, X.; Zheng, W.; Singh, D. Light scattering and surface plasmons on small spherical particles. Light. Sci. Appl. 2014, 3, e179. [Google Scholar] [CrossRef] [Green Version]
- Duque, J.S.; Blandon, J.S.; Riascos, H. Localized plasmon resonance in metal nanoparticles using Mie theory. J. Phys. Conf. Ser. 2017, 850, 012017. [Google Scholar] [CrossRef]
- Krutyakov, Y.A.; Kudrinskiy, A.A.; Olenin, A.Y.; Lisichkin, G.V. Synthesis and properties of silver nanoparticles: Advances and prospects. Russ. Chem. Rev. 2008, 77, 233–257. [Google Scholar] [CrossRef]
- Zaarour, M.; El Roz, M.; Dong, B.; Retoux, R.; Aad, R.; Cardin, J.; Dufour, C.; Gourbilleau, F.; Gilson, J.P.; Mintova, S. Photochemical preparation of silver nanoparticles supported on zeolite crystals. Langmuir 2014, 30, 6250–6256. [Google Scholar] [CrossRef] [PubMed]
- Courrol, D.D.S.; Lopes, C.R.B.; Pereira, C.B.P.; Franzolin, M.R.; Silva, F.R.O.; Courrol, L.C. Tryptophan silver nanoparticles synthesized by photoreduction method: Characterization and determination of bactericidal and anti-biofilm activities on resistant and susceptible bacteria. Int. J. Tryptophan Res. 2019, 12, 1178646919831677. [Google Scholar] [CrossRef] [Green Version]
- Carvalho, M.A.; de Paiva, R.E.F.; Bergamini, F.R.G.; Gomes, A.F.; Gozzo, F.C.; Lustri, W.R.; Formiga, A.L.B.; Shishido, S.M.; Ferreira, C.V.; Corbi, P.P. A silver complex with tryptophan: Synthesis, structural characterization, DFT studies and antibacterial and antitumor assays in vitro. J. Mol. Struct. 2013, 1031, 125–131. [Google Scholar] [CrossRef]
- Roy, S.; Das, T.K. Study of Interaction Between Tryptophan, Tyrosine, and Phenylalanine Separately with Silver Nanoparticles by Fluorescence Quenching Method. J. Appl. Spectrosc. 2015, 82, 598–606. [Google Scholar] [CrossRef]
- Nomiya, K.; Takahashi, S.; Noguchi, R.; Nemoto, S.; Takayama, T.; Oda, M. Synthesis and characterization of water-soluble silver (I) complexes with L-histidine (H2his) and (S)-(-)-2-pyrrolidone-5-carboxylic acid (H2pyrrld) showing a wide spectrum of effective antibacterial and antifungal activities. Crystal structures of chiral helical polymers [Ag(Hhis)]n and ([Ag(Hpyrrld)]2)n in the solid state. Inorg. Chem. 2000, 39, 3301–3311. [Google Scholar] [CrossRef]
- Schreurs, W.J.; Rosenberg, H. Effect of silver ions on transport and retention of phosphate by Escherichia coli. J. Bacteriol. 1982, 152, 7–13. [Google Scholar] [CrossRef] [PubMed]
- Carcamo, J.J.; Aliaga, A.E.; Clavijo, E.; Garrido, C.; Gomez-Jeria, J.S.; Campos-Vallette, M.M. Proline and hydroxyproline deposited on silver nanoparticles. A Raman, SERS and theoretical study. J. Ram. Spectr. 2012, 43, 750–755. [Google Scholar] [CrossRef]
- Tao, G.; Wang, Y.; Cai, R.; Chang, H.; Song, K.; Zuo, H.; Zhao, P.; Xia, Q.; He, H. Design and performance of sericin/poly(vinyl alcohol) hydrogel as a drug delivery carrier for potential wound dressing application. Mater. Sci. Eng. C 2019, 101, 341–351. [Google Scholar] [CrossRef] [PubMed]
- Muhammad Tahir, H.; Saleem, F.; Ali, S.; Ain, Q.U.; Fazal, A.; Summer, M.; Mushtaq, R.; Tariq Zahid, M.; Liaqat, I.; Murtaza, G. Synthesis of sericin-conjugated silver nanoparticles and their potential antimicrobial activity. J. Bas. Microbiol. 2020, 60, 458–467. [Google Scholar] [CrossRef]
- Jia, L.; Tong, L.; Liang, Y.; Petretic, A.; Guerin, G.; Manners, I.; Winnik, M.A. Templated fabrication of fiber-basket polymersomes via crystallization-driven block copolymer self-assembly. J. Am. Chem. Soc. 2014, 136, 16676–16682. [Google Scholar] [CrossRef]
- Fan, L.; Xie, J.; Zheng, Y.; Wei, D.; Yao, D.; Zhang, J.; Zhang, T. Antibacterial, Self-Adhesive, Recyclable, and Tough Conductive Composite Hydrogels for Ultrasensitive Strain Sensing. ACS Appl. Mater. Interf. 2020, 12, 22225–22236. [Google Scholar] [CrossRef]
- Dhas, S.P.; Anbarasan, S.; Mukherjee, A.; Chandrasekaran, N. Biobased silver nanocolloid coating on silk fibers for prevention of post-surgical wound infections. Int. J. Nanomed. 2015, 10, 159–170. [Google Scholar] [CrossRef] [Green Version]
- Pourhoseini, S.; Enos, R.T.; Murphy, A.E.; Cai, B.; Lead, J.R. Characterization, bio-uptake and toxicity of polymer-coated silver nanoparticles and their interaction with human peripheral blood mononuclear cells. Beil. J. Nanotechol. 2021, 12, 282–293. [Google Scholar] [CrossRef]
- Barbir, R.; Capjak, I.; Crnković, T.; Debeljak, Ž.; Domazet Jurašin, D.; Ćurlin, M.; Šinko, G.; Weitner, T.; Vinković Vrček, I. Interaction of silver nanoparticles with plasma transport proteins: A systematic study on impacts of particle size, shape and surface functionalization. Chem. Biol. Interact. 2021, 335, 109364. [Google Scholar] [CrossRef]
- Agnihotri, S.; Mukherji, S.; Mukherji, S. Size-controlled silver nanoparticles synthesized over the range 5–100 nm using the same protocol and their antibacterial efficacy. RSC Adv. 2014, 4, 3974. [Google Scholar] [CrossRef] [Green Version]

Publisher’s Note: MDPI stays neutral with regard to jurisdictional claims in published maps and institutional affiliations. |
© 2022 by the authors. Licensee MDPI, Basel, Switzerland. This article is an open access article distributed under the terms and conditions of the Creative Commons Attribution (CC BY) license (https://creativecommons.org/licenses/by/4.0/).
Share and Cite
Basov, A.; Dzhimak, S.; Sokolov, M.; Malyshko, V.; Moiseev, A.; Butina, E.; Elkina, A.; Baryshev, M. Changes in Number and Antibacterial Activity of Silver Nanoparticles on the Surface of Suture Materials during Cyclic Freezing. Nanomaterials 2022, 12, 1164. https://doi.org/10.3390/nano12071164
Basov A, Dzhimak S, Sokolov M, Malyshko V, Moiseev A, Butina E, Elkina A, Baryshev M. Changes in Number and Antibacterial Activity of Silver Nanoparticles on the Surface of Suture Materials during Cyclic Freezing. Nanomaterials. 2022; 12(7):1164. https://doi.org/10.3390/nano12071164
Chicago/Turabian StyleBasov, Alexander, Stepan Dzhimak, Mikhail Sokolov, Vadim Malyshko, Arkadii Moiseev, Elena Butina, Anna Elkina, and Mikhail Baryshev. 2022. "Changes in Number and Antibacterial Activity of Silver Nanoparticles on the Surface of Suture Materials during Cyclic Freezing" Nanomaterials 12, no. 7: 1164. https://doi.org/10.3390/nano12071164
APA StyleBasov, A., Dzhimak, S., Sokolov, M., Malyshko, V., Moiseev, A., Butina, E., Elkina, A., & Baryshev, M. (2022). Changes in Number and Antibacterial Activity of Silver Nanoparticles on the Surface of Suture Materials during Cyclic Freezing. Nanomaterials, 12(7), 1164. https://doi.org/10.3390/nano12071164

